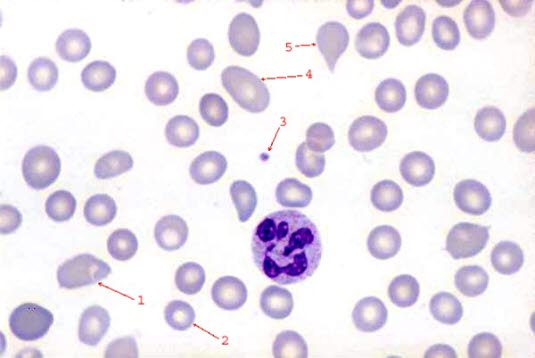
Makrocytær anemi (x 100) Makrocytær anemi (x 100)

Bilde
Makrocytær anemi
Sist oppdatert:
20. apr. 2017

100 x forstørrelse. Blodmangel (anemi) karakterisert ved uvanlig store røde blodceller (makrocytære). Her ses dessuten stor variasjon i størrelse og form av de røde blodcellene.
Sist oppdatert:
20. apr. 2017
100 x forstørrelse. Blodmangel (anemi) karakterisert ved uvanlig store røde blodceller (makrocytære). Her ses dessuten stor variasjon i størrelse og form av de røde blodcellene.